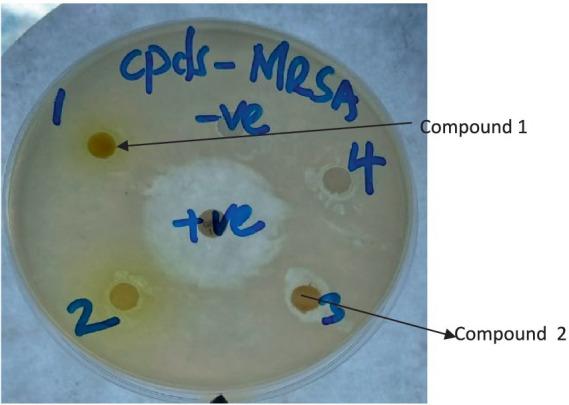
https://cdn.ncbi.nlm.nih.gov/pmc/blobs/1ec9/12237972/82c5769001b9/fmicb-16-1604820-g003.jpg

来自[具体来源]的无环二酯、油酸和十四烷酸β-香树脂醇酯对耐抗生素细菌的抗菌效力。
Antibacterial potency of acyclic diester, oleic acid, and -amyrin tetradecanoate from and against antibiotic-resistant bacteria.
作者信息
Kimutai Nicholas Kogo, Ogutu Philip A, Kamau Rahab, Mutai Charles
机构信息
Department of Biological Sciences, Masinde Muliro University of Science and Technology, Kakamega, Kenya.
Department of Pure and Applied Chemistry, Masinde Muliro University of Science and Technology, Kakamega, Kenya.
出版信息
Front Microbiol. 2025 Jun 25;16:1604820. doi: 10.3389/fmicb.2025.1604820. eCollection 2025.
INTRODUCTION
The increase in antibiotic-resistant microorganisms has led to the search of new and effective antimicrobial agents. Natural products from plants may, therefore, serve as alternative sources of substances for the treatment of these infections. Traditional practitioners use concoctions of and extracts for the treatment of wounds, skin diseases, coughs, ulcers, and intestinal ailments. This is because they are rich in potent antibacterial compounds. The objective of this study was to isolate bioactive compounds from and using bioassay-guided fractionation.
METHODS
Bioactivity testing was performed against selected microbes using disc diffusion and broth microdilution methods, as recommended by the Clinical and Laboratory Standards Institute (CLSI). Pure compounds were isolated using chromatographic procedures, and their structures were elucidated based on 1D and 2D NMR analyses.
RESULTS
Fractionation yielded two fatty acids, namely, 5-(2, 5-dimethylhexyl) 1-isopentyl 3-hydroxy-2-methylpentanedioate (acyclic diester) () and oleic acid () from and , respectively. In addition, yields terpenoid -amyrin tetradecanoate (). The three compounds were selectively active against the tested microorganisms, with minimum inhibitory concentrations (MICs) of 25.0 mg/mL and 100.0 mg/mL shown by oleic acid and -amyrin tetradecanoate against , respectively. These two compounds were isolated and tested for antibacterial activity against this plant for the first time. In addition, an acyclic diester named 5-(2, 5-dimethylhexyl) 1-isopentyl 3-hydroxy-2-methylpentanedioate () was isolated and screened for antibacterial activity for the first time from the extracts of
CONCLUSION
and extracts and compounds showed antibacterial activity against multidrug-resistant bacteria. This study provides valuable insights into the development of effective antimicrobial agents.
引言
抗生素耐药微生物的增加促使人们寻找新的有效抗菌剂。因此,植物中的天然产物可能成为治疗这些感染的物质的替代来源。传统从业者使用[植物名称1]和[植物名称2]提取物的混合物来治疗伤口、皮肤病、咳嗽、溃疡和肠道疾病。这是因为它们富含强效抗菌化合物。本研究的目的是通过生物测定导向分级分离从[植物名称1]和[植物名称2]中分离生物活性化合物。
方法
按照临床和实验室标准协会(CLSI)的建议,使用纸片扩散法和肉汤微量稀释法对选定的微生物进行生物活性测试。使用色谱程序分离纯化合物,并基于一维和二维核磁共振分析阐明其结构。
结果
分级分离分别从[植物名称1]和[植物名称2]中得到两种脂肪酸,即5-(2,5-二甲基己基)1-异戊基3-羟基-2-甲基戊二酸酯(无环二酯)([化合物名称1])和油酸([化合物名称2])。此外,[植物名称1]产生萜类化合物十四烷酸β-香树脂醇酯([化合物名称3])。这三种化合物对测试的微生物具有选择性活性,油酸和十四烷酸β-香树脂醇酯对[微生物名称]的最低抑菌浓度(MICs)分别为25.0mg/mL和1oo.0mg/mL。这两种化合物首次被分离并测试对该植物的抗菌活性。此外,一种名为5-(2,5-二甲基己基)1-异戊基3-羟基-2-甲基戊二酸酯([化合物名称1])的无环二酯首次从[植物名称1]的提取物中分离出来并进行抗菌活性筛选。
结论
[植物名称1]和[植物名称2]的提取物及化合物对多重耐药细菌显示出抗菌活性。本研究为开发有效的抗菌剂提供了有价值的见解。